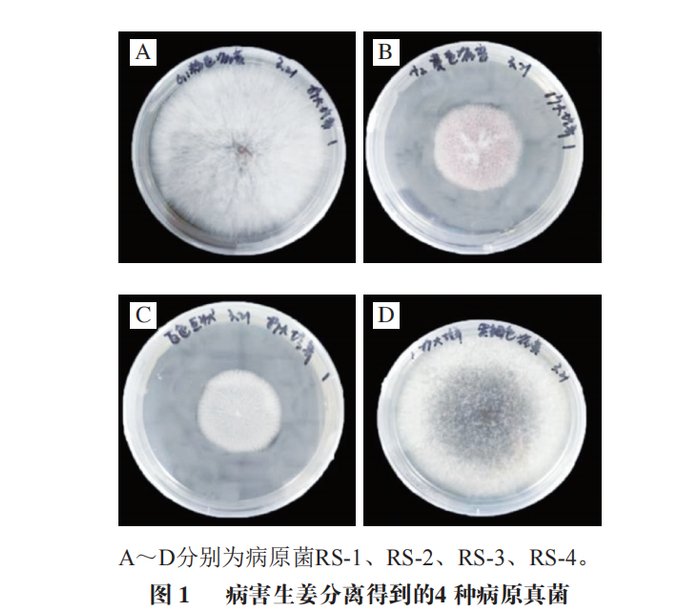
浙江省农业科学院陈杭君研究员等:鲜姜采后禾谷镰刀菌侵染过程

禾谷镰刀菌的菌落形态

perithecium formation and ascospore discharge in
图片尺寸1941x1184
perithecium formation and ascospore discharge in
图片尺寸1072x1310
一等奖作品:齐朝妹-禾谷镰刀菌野生型ph-1子囊壳横切面
图片尺寸500x374
镰刀菌
图片尺寸572x480
浙江省农业科学院陈杭君研究员等:鲜姜采后禾谷镰刀菌侵染过程
图片尺寸700x773
镰刀菌属
图片尺寸264x315
镰刀菌属
图片尺寸501x470
镰刀菌属
图片尺寸1600x1200
一种诱导禾谷镰刀菌大量产孢及制备孢子液方法
图片尺寸443x334
层生镰刀菌菌落形态 背面sda 28℃ 3天a.
图片尺寸660x686
这就是假禾谷镰刀菌电镜下大分生孢子的形态三,为害特点该病在小麦
图片尺寸550x311
sbio | 许金荣/江聪团队报道禾谷镰刀菌mapks介导的生长发育,逆境响应
图片尺寸1080x1351
tharzianum镰刀菌素茎腐病的强力克星
图片尺寸1650x2120
禾谷镰刀菌病
图片尺寸316x238
浙江省农业科学院陈杭君研究员等:鲜姜采后禾谷镰刀菌侵染过程
图片尺寸700x611
一株用于抑制镰孢菌产孢能力和分生孢子生长发育的假禾谷镰孢菌株wh
图片尺寸591x287
用倒置显微镜拍的照片大家看一下是镰刀菌吗为什么孢子不像镰刀型啊
图片尺寸800x599
一种禾谷镰刀菌单链环状dna病毒fggmtv1hb58及其应用的制作方法
图片尺寸940x927
newphyto西北农林科技大学在禾谷镰刀菌有性生殖和侵染致病方面取得新
图片尺寸523x481
的禾谷镰刀菌接种于pda平板中心,12 h后,培养基表面已有白色菌落生成
图片尺寸731x853